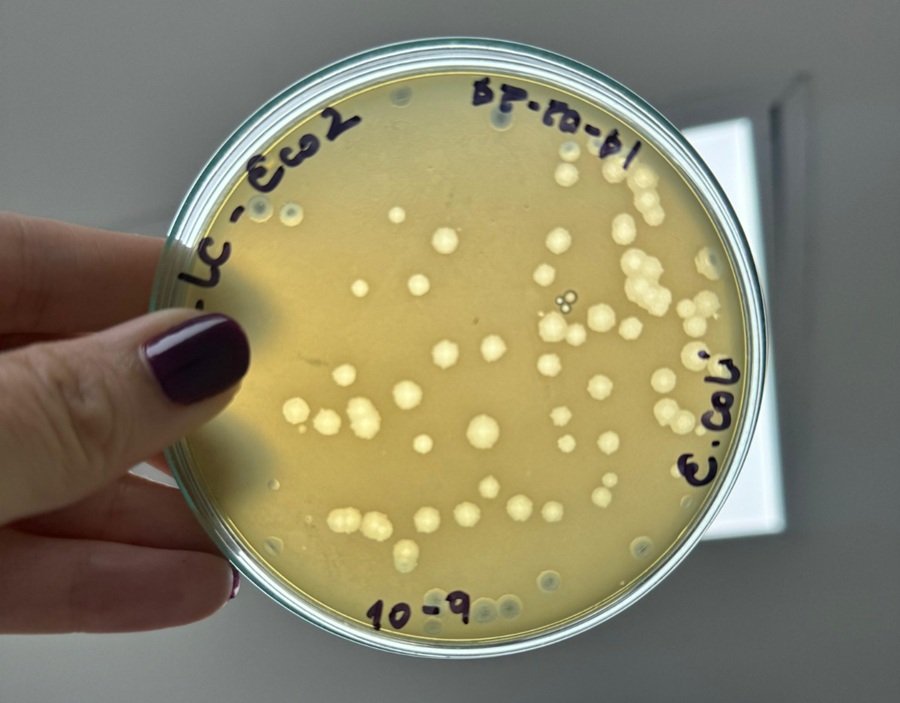

Investigación de la Unicórdoba demuestra que virus pulverizado prolonga conservación del queso costeño
Montería, Córdoba. En un nuevo desarrollo tecnológico, docentes – científicos del programa de Ingeniería de Alimentos de la Universidad de Córdoba, aislaron de la línea de producción de queso costeño un bacteriófago o virus bueno para combatir dos bacterias identificadas como Escherichia coli (E. coli) y Salmonella, capaces de generar enfermedades cuando las buenas prácticas de manufactura no se ejecutan de la mejor forma.
Es la primera vez que esta especie de virus es relatada en la literatura científica, lo que indica que los resultados de la investigación, que ya está al servicio de los productores de la región, abre el estado del arte en el enfoque que lideran los docentes Maryoris Soto López y Omar Pérez Sierra, soportados en un trabajo en equipo desde el Grupo de Investigación en Procesos y Propiedades Alimentarias (Gippal), establecido en Categoría A, por el Ministerio de Ciencia, Tecnología e Innovación, tras 15 años de trayectoria.
“Son muy raros los virus en el mundo que tienen la capacidad de ser polivalentes, es decir, que son capaces de comerse más de una especie; es decir, este fue un dos por uno que aislamos en nuestros laboratorios desde nuestro grupo de investigación. Esta solución a través del virus mencionado es capaz de extender la vida útil del queso costeño y propiciar beneficios para mantener íntegras las características y propiedades nutricionales”, explica la docente e investigadora Soto López.
Destaca la docente unicordobesa, programa de Ingeniería de Alimentos, que la investigación ha sido sostenida, además, por estudiantes de doctorado y maestría interesados en avanzar en el tema de los bacteriófagos, toda vez que se trata de un enfoque aplicable a la industria médica, a la industria animal y de manera general a la producción de alimentos. Esta investigación permitió la sustentación de la tesis del primer candidato a doctor en Ciencia y Tecnología de Alimentos, en Unicórdoba, con el tema: ‘Desarrollo de Productos Fágicos como Herramienta de Biocontrol de Escherichia coli para Mejorar la Inocuidad del Queso Costeño’, por el ingeniero Fernando Mendoza Corvis.
El virus pulverizado es un bioproducto a base de fagos, que facilitará a los productores el proceso, y que se alimentará de las bacterias, secuestrando su maquinaria celular.
El profesor Omar Pérez Sierra, coautor de la investigación, explica que el producto final convertido en polvo es encapsulado para la protección de este y suministrado a los productores junto a instrucciones precisas de dosificación, para la elaboración del apetecido producto en las mesas y en las cocinas del Caribe colombiano.
“Se trata de un bioproducto a base de fagos, que facilitará a los productores el proceso, y que se alimentará de las bacterias, secuestrando su maquinaria celular, eso le permitirá replicarse y perdurar en el tiempo”, sostiene el científico unicordobés Pérez Sierra, docente del programa de Ingeniería de Alimentos, Facultad de Ingenierías.
El virus pulverizado y encapsulado por la Universidad de Córdoba ha recibido como nombre UNICOR_HM-QL, en honor a la alma mater, mientras que las dos últimas letras responden a que fue aislado de la cadena productiva de quesos de Lorica.
El proyecto ha sido financiado por Unicórdoba y por el Ministerio de Ciencia y Tecnología (MinCiencias) y para llegar a resultados se ha trabajado con unos 200 pequeños y medianos productores de queso costeño en Córdoba, de municipios como: Lorica, Planeta Rica, Chimá, Cereté, Tierralta y Ciénaga de Oro, con quienes se han compartido todas las tecnologías que desarrolla el grupo de investigación, con miras a mejorar la inocuidad de los productos autóctonos.











